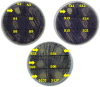

Detection of quorum sensing signal molecules and identification of an autoinducer synthase gene among biofilm forming clinical isolates of Acinetobacter spp
- PMID: 22815678
- PMCID: PMC3398020
- DOI: 10.1371/journal.pone.0036696
Detection of quorum sensing signal molecules and identification of an autoinducer synthase gene among biofilm forming clinical isolates of Acinetobacter spp
Abstract
Background: Quorum sensing is a term that describes an environmental sensing system that allows bacteria to monitor their own population density which contributes significantly to the size and development of the biofilm. Many gram negative bacteria use N-acyl-homoserine lactones as quorum sensing signal molecules. In this study, we sought to find out if the biofilm formation among clinical isolates of Acinetobacter spp. is under the control of autoinducing quorum sensing molecules.
Methodology/principal findings: Biofilm formation among clinical isolates of Acinetobacter spp. was assessed and the production of signal molecules were detected with Chromobacterium violaceum CV026 biosensor system. Characterisation of autoinducers was carried out by mass spectrometric analysis. We have also reported the identification of an autoinducer synthase gene, abaΙ among the isolates that produce quorum sensing signal molecules and have reported that the mutation in the abaI gene influences their biofilm forming capabilities. Using a microtitre-plate assay it was shown that 60% of the 50 Acinetobacter spp. isolates significantly formed biofilms. Further detection with the biosensor strain showed that some of these isolates produced long chain signal molecules. Mass spectrometric analysis revealed that five of these isolates produced N-decanoyl homoserine lactone and two isolates produced acyl-homoserine lactone with a chain length equal to C(12). The abaΙ gene was identified and a tetracycline mutant of the abaΙ gene was created and the inhibition in biofilm formation in the mutant was shown.
Conclusions/significance: These data are of great significance as the signal molecules aid in biofilm formation which in turn confer various properties of pathogenicity to the clinical isolates including drug resistance. The use of quorum sensing signal blockers to attenuate bacterial pathogenicity is therefore highly attractive, particularly with respect to the emergence of multi antibiotic resistant bacteria.
Conflict of interest statement
Figures

References
-
- Hartstein AI, Rashad AL, Liebler JM, Actis LA, Freeman J, et al. Multiple intensive care unit outbreak of Acinetobacter calcoaceticus subspecies anitratus respiratory infection and colonisation associated with contaminated, reusable ventilator circuits and resuscitation bags. Am. J. Med. 1988;85:624–631. - PubMed
-
- Falagas ME, Karveli EA. The Changing Global Epidemiology of Acinetobacter baumannii Infections: a development with Major Public Health Implications. Clinic. Mirobial. Infect. 2007;13:117–119. - PubMed
-
- Talbot G H, Bradley J, Edwards JE, Gilbert D, Scheld M, et al. Bad bugs need drugs: an update on the development pipeline from the antimicrobial availability task force of the Infectious Disease Society of America. Clin. Infect. Dis. 2006;42:657–668. - PubMed
Publication types
MeSH terms
Substances
LinkOut - more resources
Full Text Sources
Molecular Biology Databases
Miscellaneous

